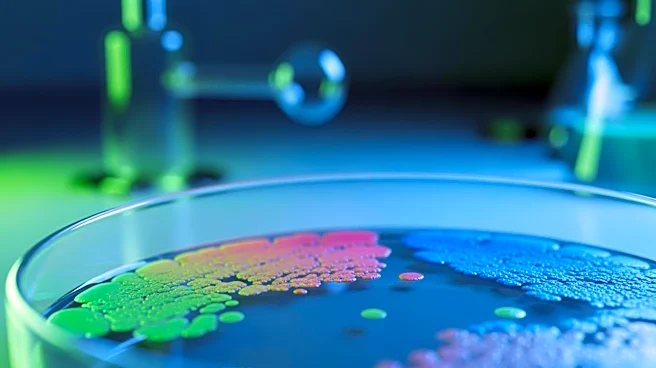

What's Happening?
Researchers are increasingly concerned about the rising incidence of colorectal cancer among younger adults, particularly those in their 30s and 40s. Dr. Ning Jin, an oncologist at The Ohio State University, notes that these younger patients often present
with more aggressive and treatment-resistant tumors. Despite advancements in cancer treatment, colorectal cancer remains a leading cause of cancer-related deaths in individuals under 50. The gut microbiome is suspected to play a significant role in this trend, with environmental factors such as diet and chemical exposure potentially disrupting the gut's protective mucus layer. This disruption may lead to conditions like 'leaky gut,' which can contribute to cancer development.
Why It's Important?
The increase in colorectal cancer cases among younger populations poses a significant public health challenge. Traditionally, preventive screenings for colorectal cancer are recommended starting at age 45, but the shift in age demographics suggests a need for earlier diagnostic testing. This trend highlights potential gaps in current healthcare guidelines and insurance coverage, which may not adequately address the needs of younger individuals at risk. Understanding the environmental and lifestyle factors contributing to this rise is crucial for developing effective prevention and treatment strategies. The findings could lead to changes in public health policies and recommendations, potentially impacting insurance practices and healthcare costs.
What's Next?
Further research is needed to pinpoint the exact environmental factors and microbiome changes contributing to the rise in colorectal cancer among younger adults. Scientists are calling for more controlled studies to explore the interactions within the microbiome and their link to cancer. Additionally, there may be a push for earlier and more frequent screenings for at-risk populations, particularly those with a family history of colorectal cancer. Healthcare providers and policymakers may need to consider revising current screening guidelines and insurance coverage to better accommodate these emerging trends.
Beyond the Headlines
The potential link between lifestyle changes, such as increased consumption of ultra-processed foods and reduced physical activity, and the rise in colorectal cancer cases underscores broader societal shifts. These changes may not only affect cancer rates but also contribute to other health issues. The research into the microbiome's role in cancer development could lead to a deeper understanding of how modern lifestyles impact overall health, potentially influencing future dietary and lifestyle recommendations.